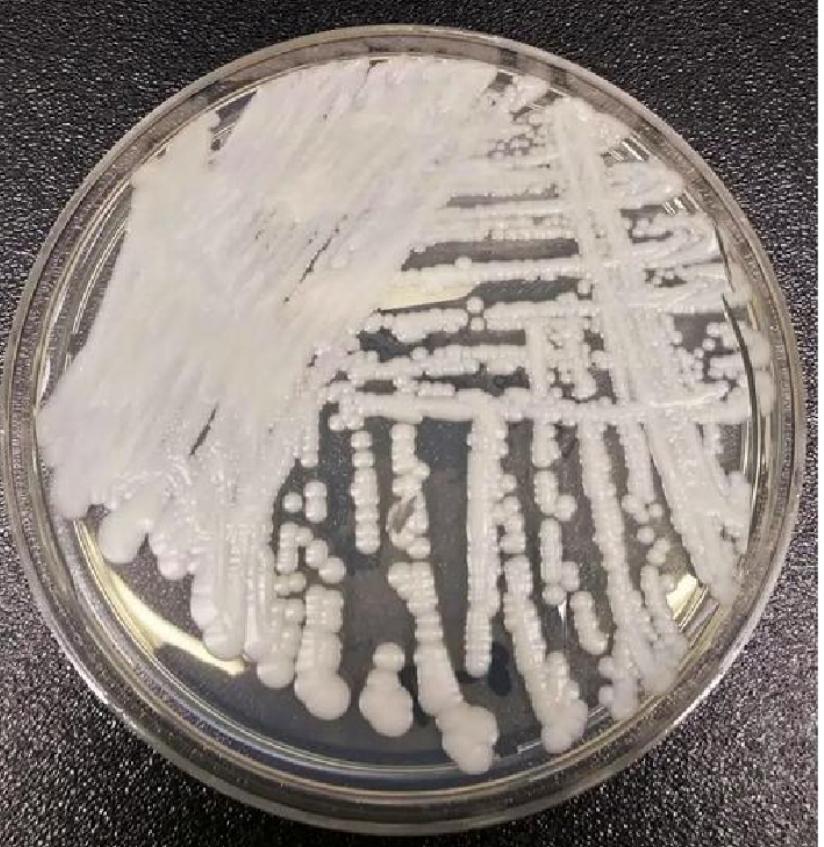

返回顶部
返回顶部
耳念珠菌在华南地区并不少见,广东专家:未发生集中爆发流行
文/羊城晚报全媒体记者 陈辉
通讯员 彭福祥
近两日“耳念珠菌”让人闻风丧胆,这种真菌已席卷美国一半以上的州,且近半数感染者会在90天内死亡。羊城晚报记者从中山大学附属第一医院耳鼻咽喉科获悉,华南地区天气潮湿,外耳道真菌感染常见,耳念珠菌是其中真菌之一,病例并不少见,但绝大多数为局部感染,念珠菌对健康人群的威胁很小,公众不必恐慌,无须采取特殊的预防措施。
潮湿地区,耳念珠菌感染并不少见
美国当地时间3月20日,美国疾病控制与预防中心(CDC)在一项最新研究中警告称,耳念珠菌正以“惊人的速度”在美国传播开来,截至去年12月已蔓延全美一半以上的州,成为紧急公共卫生威胁,这种病菌具有强耐药性和较高的致死率,近半数感染耳念珠菌的患者会在90天内死亡。
这么可怕的耳念珠菌是新发现的微生物吗?中山一院耳鼻咽喉科吴旋教授介绍,耳念珠菌是一种近年来新发现的真菌,2009年日本医生在一名患者的外耳道分泌物中发现并首次报道,因其最先从外耳道发现,所以称为耳念珠菌。他在耳科门诊出诊时其实经常会接诊耳念珠菌患者,这可能与华南地区天气潮湿有一定关系。这些患者多是因耳奇痒、耳闷、耳痛而来就诊的,感染原因一般与慢性化脓性中耳炎或者长期不洁掏耳朵的习惯有关。医生会在这些患者的外耳道内看见白色粉末状或绒毛状真菌。这些患者的症状只是局限在耳朵,经过一段时间规范治疗后都能痊愈。

这几类人感染后症状会重
吴旋教授介绍,耳念珠菌感染后引起严重危害的并非没有,他们偶尔会在重症监护室遇到,有患者因耳念珠菌感染引起了败血症,而出现高热、寒战、呼吸困难、休克等。
由于重症监护的患者免疫力都比较低,如果里面一旦发现有患者感染耳念珠菌,会马上转入单独的病房,以避免交叉感染。
感染耳念珠菌后引起严重危害的,主要会发生在免疫功能低下或缺陷的人群中。包括长期使用广谱抗生素、类固醇激素或抗真菌药物的人群;使用中心静脉导管、呼吸管、饲管和膀胱导管的人群;长期住院或卧床的人群;HIV感染者、癌症患者、器官移植患者、糖尿病患者等。
耳念珠菌可通过血液、尿液、呼吸道分泌物、伤口和中心静脉导管引起全身感染,如败血症,而危及患者生命安全。
吴旋表示,耳念珠菌并不可怕,对健康人群威胁小,但免疫力低下人群需注意避免交叉感染。美国的情形为何这么吓人?吴旋教授介绍,目前有观点认为,在美国流行的或是耳念珠菌特殊菌株。

如何预防耳念珠菌
【保持良好的个人卫生及清洁】常洗手,尤其是在接触患者或公共用品之后;避免使用不干净的工具掏耳朵;避免共用洗漱品,公用浴巾、浴盆等。
【保持健康的生活方式】如规律作息、均衡饮食、适当锻炼,增强自身抵抗力。
避免滥用抗生素和抗真菌药物。
【特殊人群中采取预防措施】在医院ICU和养老院等场所需遵循适当的感染控制措施,佩戴好口罩、配合医护定期消毒医用设备和环境。
耳念珠菌在全球发病情况如何?
目前,全球已有三十多个国家发现耳念珠菌感染病例。
近三年来,由于新冠疫情影响及住院重症患者大量增加,耳念珠菌在美国出现较为严重的流行传播,可能与发生于该国某些类型的耳念珠菌的多重耐药性、传播性强,引起耳念珠菌败血症后却无法通过药物控制,因而死亡率高。
我国此前报道的耳念珠菌感染病例均为散发病例,没有发生集中暴发或者流行倾向。(更多新闻资讯,请关注羊城派 pai.ycwb.com)
来源 | 羊城晚报·羊城派
责编 | 薛仁政
校对 | 谢志忠
 返回顶部
返回顶部


f640d6fe-fec6-411d-acd4-5f04445865b1.jpg)











